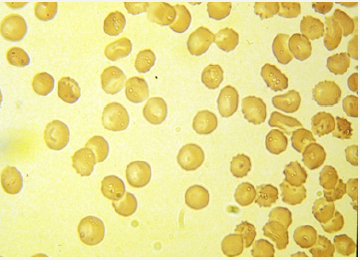
Click here to view Large image 4

Hit Kishore Goswami*
Department of Genetics, Barkatullah University, India
*Corresponding author: Hit Kishore Goswami, Retired Professor of Genetics, Barkatullah University, Bhopal 24, Kaushalnagar, P.O. Misrod, Bhopal, Madhya Pradesh, 462047, India
Submission: January 25, 2018;Published: February 28, 2018
ISSN: 2578-0069Volume1 Issue3
Based on field work in tribal areas/isolated settled populations and family studies over several years this short note describes the importance of orthopaedic clinics which can also monitor many hemoglobin disorders by undertaking family studies for genetic counseling.
Keywords: Hemoglobin disorders and orthopaedic complications; Genetic significance of deformations; Orthopaedic clinics; Evolutionary significance of skeletal disorders; Field surveys in remote areas to search bony deformities.
Anatomically, Homo sapiens the man, is architecturally shaped, designed and trimmed by biological evolution in such a way that each and every organ of the body with skeletal support appears to be a perfect highly evolved individual in the Animal Kingdom. Genetic involvements (viz. simple gene actions, complex interactions, multiple genes, chromosomes and chromosomal aberrations etc) and immediate environmental interactions thereby influencing selection pressures (including natural selection) have finally offered almost a stable shape during these billions of years of evolutionary pathway. Orthopaedic evolution in man in particular, has been the most exemplary in the geometrical proportions of the human body so as to enable him to survive with enormous flexibility of adaptive responses.
The most well known example is the evolution of skull shape which was in the primitive man not semicircular but had triangular or raised furrow in the middle making such individuals prone to highly susceptible to falling of tree-branches/stone or any such heavy item falling on the head. Mutations assisted with natural selection have had given a semicircular top to the skull which is quite strong and safe; obviously, skull is the cage to the most sensitive and highly evolved organ, the brain possessed by our species. So on one hand we consider the man as highly evolved species, the frequency of congenital malformations observed world over opine that we are not [1,2] and are still under screening of natural selection. The spectrum of anomalies is extensive; ranging from hidden defects of internal organs, heart and kidney or intestines, to visible developmental defects like harelip, or deformities of limbs and even cerebrum. Among congenital traits the most alarming traits are orthopaedic complications visible at birth. Furthermore, most these congenital traits are developmental errors caused by the genic interactions, molecular mechanisms at the DNA level, and or, also due to chromosomal involvements.
This short note points to such common traits with which a child/ person comes with a different complaint but intellectual screening ends up in genetic counseling approach and offer guide lines for the treatment not only to the patient/ person but also to the entire family. Several text books and research papers have presented hundreds of disorders involving skeletal deformities or developmental errors in man [3,4] but hereunder only those which are relatively commonly observed are briefly presented.
Participation and collaboration with medical personnel in GR Medical college at Gwalior enabling the author to attend special classes and clinics in the departments of neurosurgery, paediatrics, gynaecology & obstetrics and anatomy departments during 1967- 1976 forms the major background for such investigations [5- 7] partly outlined in this short note. Later such clinics were also attended at Gandhi Medical College, Bhopal during 1978 onwards until the year 2000 and a large number of interesting investigations have been published. The zest of this note is that a person or a patient attending an orthopaedic clinic with a relevant complaint may actually be demonstrating involvement of some or the other genetic involvement and such patients can offer valuable information for teaching medical genetics. Here, not only the person in question but also his/her family members need to be studied and counseled adequately. Necessary investigations were made by pathologists and technicians for the diagnosis at the respective departments.
Some uncommon orthopaedic traits are presented here under:
Figure 1: Brachydactylous palms.

a. Brachydactyly: Brachydactyly (Figure 1) is a rare trait in man known to be the first dominant trait described in Mendelian terms by Farabee in 1903 [6]. This trait can also be termed as “gene action, par excellence” because the trait is visible on birth. Both palms are affected and one phalange is fused and or absent thus reducing to only two instead of three phalanges. Goswami & Chaurasia [6] had discovered a person with only one palm affected while the other palm was quite normal. Additionally, the subject also possessed absent of great toe and metatarsals in both feet and more plausible explanation was offered by interacting two genes. The inheritance of brachydactylies is now considered to be by two interacting genes as sometimes phenotypically some other bony deformities may also be visibly associated.
b. Marfan’s syndrome: This is another trait observed at birth with proportionately longer limb extremities; both phalanges and metatarsals are long and child appears to be taller. We presume this to be a polygenic trait.
Figure 2: Postoperative.

c. Hairs on end: A patient with frequent headache and weakness was referred to the clinic and was diagnosed with enlarged spleen. On X-ray examination, as expected the skull showed outer margin lined by hair like projection (Figure 2) all along semicircular periphery of the skull. This is well documented text book affiliation with B (beta) thalassemia and a classical demonstration of multiple gene-interacting trait [8].
d Femur head necrosis: Sickle cell anaemia (aa) patients suffer from a severe haemolytic anaemia. Hypoxia results in malformed bony face; growing age results in femur head necrosis. At molecular level, substitution of the aminoacid valine for the glutamic acid, that normally is the sixth aminoacid in the beta globin polypeptide chain. Mutation CTC to a CAC in the DNA, corresponding to RNA codons GAG to GUG resulted in crystallizing haemoglobin in low oxygen conditions there by bending/loosened plasma membrane of red blood cells. Patients experience non ending pains in joints.
Figure 3: Typical lobster’s foot; note variable penetrance and syndactyly.

Figure 4: Blood smear of a severely affected person with Lobster’s foot also showing alpha thalassemia. Note the spiny plasmamembrane in some cells.
e. Lobster’s Foot: The Lobster’s Foot (Figure 3) is a very rare recessively inherited trait [9,10] which exhibits bisecting or splitting of the feet. Goswami [7] has reported variable phenotypes among some consanguineously as well as none consanguineously related couples and segregations in families in Bhopal (Central India) have suggested interaction of multiple genes along with a few individuals demonstrating variable penetrance even in the feet of the same individuals. In one sib the foot was deeply furrowed with syndactyly in metatarsals; but in all cases the great toes were always intact and well developed. This patient also showed hypoxic red blood cells suggesting minor thalassemia and peculiarly enough, about 50% of RBCs showed spiny plasma membrane (Figure 4). HbF estimations were also higher but probably with no apparent significance. Non cooperative attitude of family members did not allow further investigations.
f. Several families with peroneal atrophy, muscular dystrophies and peculiarly shaped skull variations but not deformities have been studied and the simple blood smears stained with eosin have always convinced that in all skeletal defects the RBCs by and large do not exhibit as “Full &healthy look” as these appear in a normal healthy adult.
g. Additionally, those interested in human evolution may find that on extensive field work in tribal areas (isolated populations) we often come across many adults (more than 50 years) very thin, measuring only four feet or so; weighing less than 45Kg (resembling Homo habilis phenotype). I have also witnessed protruding skull margins over eyebrows with backwardly bent - flat forehead simulating Homo erectus as documented in the fossil skull [11]. X-ray pictures of many skeletal deformities do indicate inherent features of evolutionary importance making search of X-ray repository worth reinvestigating [12].
© 2018 Hit Kishore Goswami. This is an open access article distributed under the terms of the Creative Commons Attribution License , which permits unrestricted use, distribution, and build upon your work non-commercially.
a Creative Commons Attribution 4.0 International License. Based on a work at www.crimsonpublishers.com.
Best viewed in